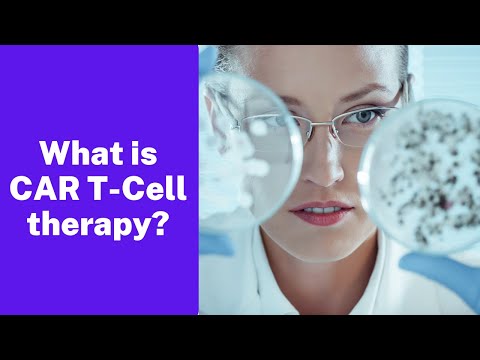

Welcome to CancerFax – Conquering Cancer
At CancerFax, we help patients access advanced and innovative cancer treatments across China. From CAR T-cell therapy, TIL therapy, NK cell therapy, CIK therapy, to cutting-edge gene therapy, we connect you with top hospitals, leading oncologists, and global clinical trials.
💡 Why Choose Us?
Personalized guidance for cancer patients
Direct access to top-tier Chinese cancer hospitals
Affordable, world-class therapies not available elsewhere
🎯 Empowering hope, saving lives – one patient at a time.
🔔 Subscribe to stay updated on global cancer breakthroughs, survivor stories, clinical trials, and treatment options.
Follow us:
Facebook: www.facebook.com/cancerfax
Twitter: twitter.com/cancerfax
Instagram: instagram.com/cancerfax
YouTube: youtube.com/@cancerfax